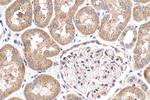
Phospholipase C epsilon 1 Antibody in Immunohistochemistry (Paraffin) (IHC (P))
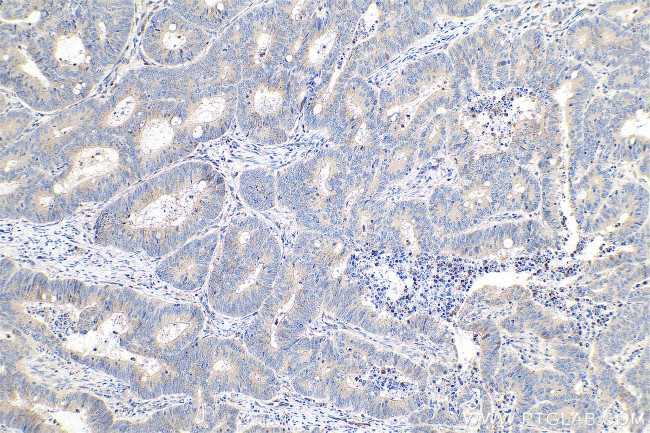
Phospholipase C epsilon 1 Antibody in Immunohistochemistry (Paraffin) (IHC (P))

Search
Proteintech
Phospholipase C epsilon 1 Polyclonal Antibody
{{$productOrderCtrl.translations['antibody.pdp.commerceCard.promotion.promotions']}}
{{$productOrderCtrl.translations['antibody.pdp.commerceCard.promotion.viewpromo']}}
{{$productOrderCtrl.translations['antibody.pdp.commerceCard.promotion.promocode']}}: {{promo.promoCode}} {{promo.promoTitle}} {{promo.promoDescription}}. {{$productOrderCtrl.translations['antibody.pdp.commerceCard.promotion.learnmore']}}
图: 1 / 5
Phospholipase C epsilon 1 Antibody (55463-1-AP) in IHC (P)

产品信息
55463-1-AP
种属反应
宿主/亚型
分类
类型
抗原
偶联物
形式
浓度
规格
纯化类型
保存液
内含物
保存条件
运输条件
靶标信息
This gene encodes a phospholipase enzyme that catalyzes the hydrolysis of phosphatidylinositol-4,5-bisphosphate to generate two second messengers: inositol 1,4,5-triphosphate (IP3) and diacylglycerol (DAG). These second messengers subsequently regulate various processes affecting cell growth, differentiation, and gene expression. This enzyme is regulated by small monomeric GTPases of the Ras and Rho families and by heterotrimeric G proteins. In addition to its phospholipase C catalytic activity, this enzyme has an N-terminal domain with guanine nucleotide exchange (GEF) activity. Mutations in this gene cause early-onset nephrotic syndrome; characterized by proteinuria, edema, and diffuse mesangial sclerosis or focal and segmental glomerulosclerosis. Alternative splicing results in multiple transcript variants encoding distinct isoforms.
仅用于科研。不用于诊断过程。未经明确授权不得转售。
篇参考文献 (0)
生物信息学
蛋白别名: 1-phosphatidylinositol 4,5-bisphosphate phosphodiesterase epsilon-1; Pancreas-enriched phospholipase C; phosphoinositide phospholipase C; Phosphoinositide phospholipase C-epsilon-1; phosphoinositide-specific phospholipase C epsilon-1; Phospholipase C-epsilon-1; PLC-epsilon-1; pPLC; similar to CePLC210; unnamed protein product
基因别名: KIAA1516; NPHS3; PLCE; PLCE1; PPLC
UniProt ID: (Human) Q9P212
Entrez Gene ID: (Human) 51196